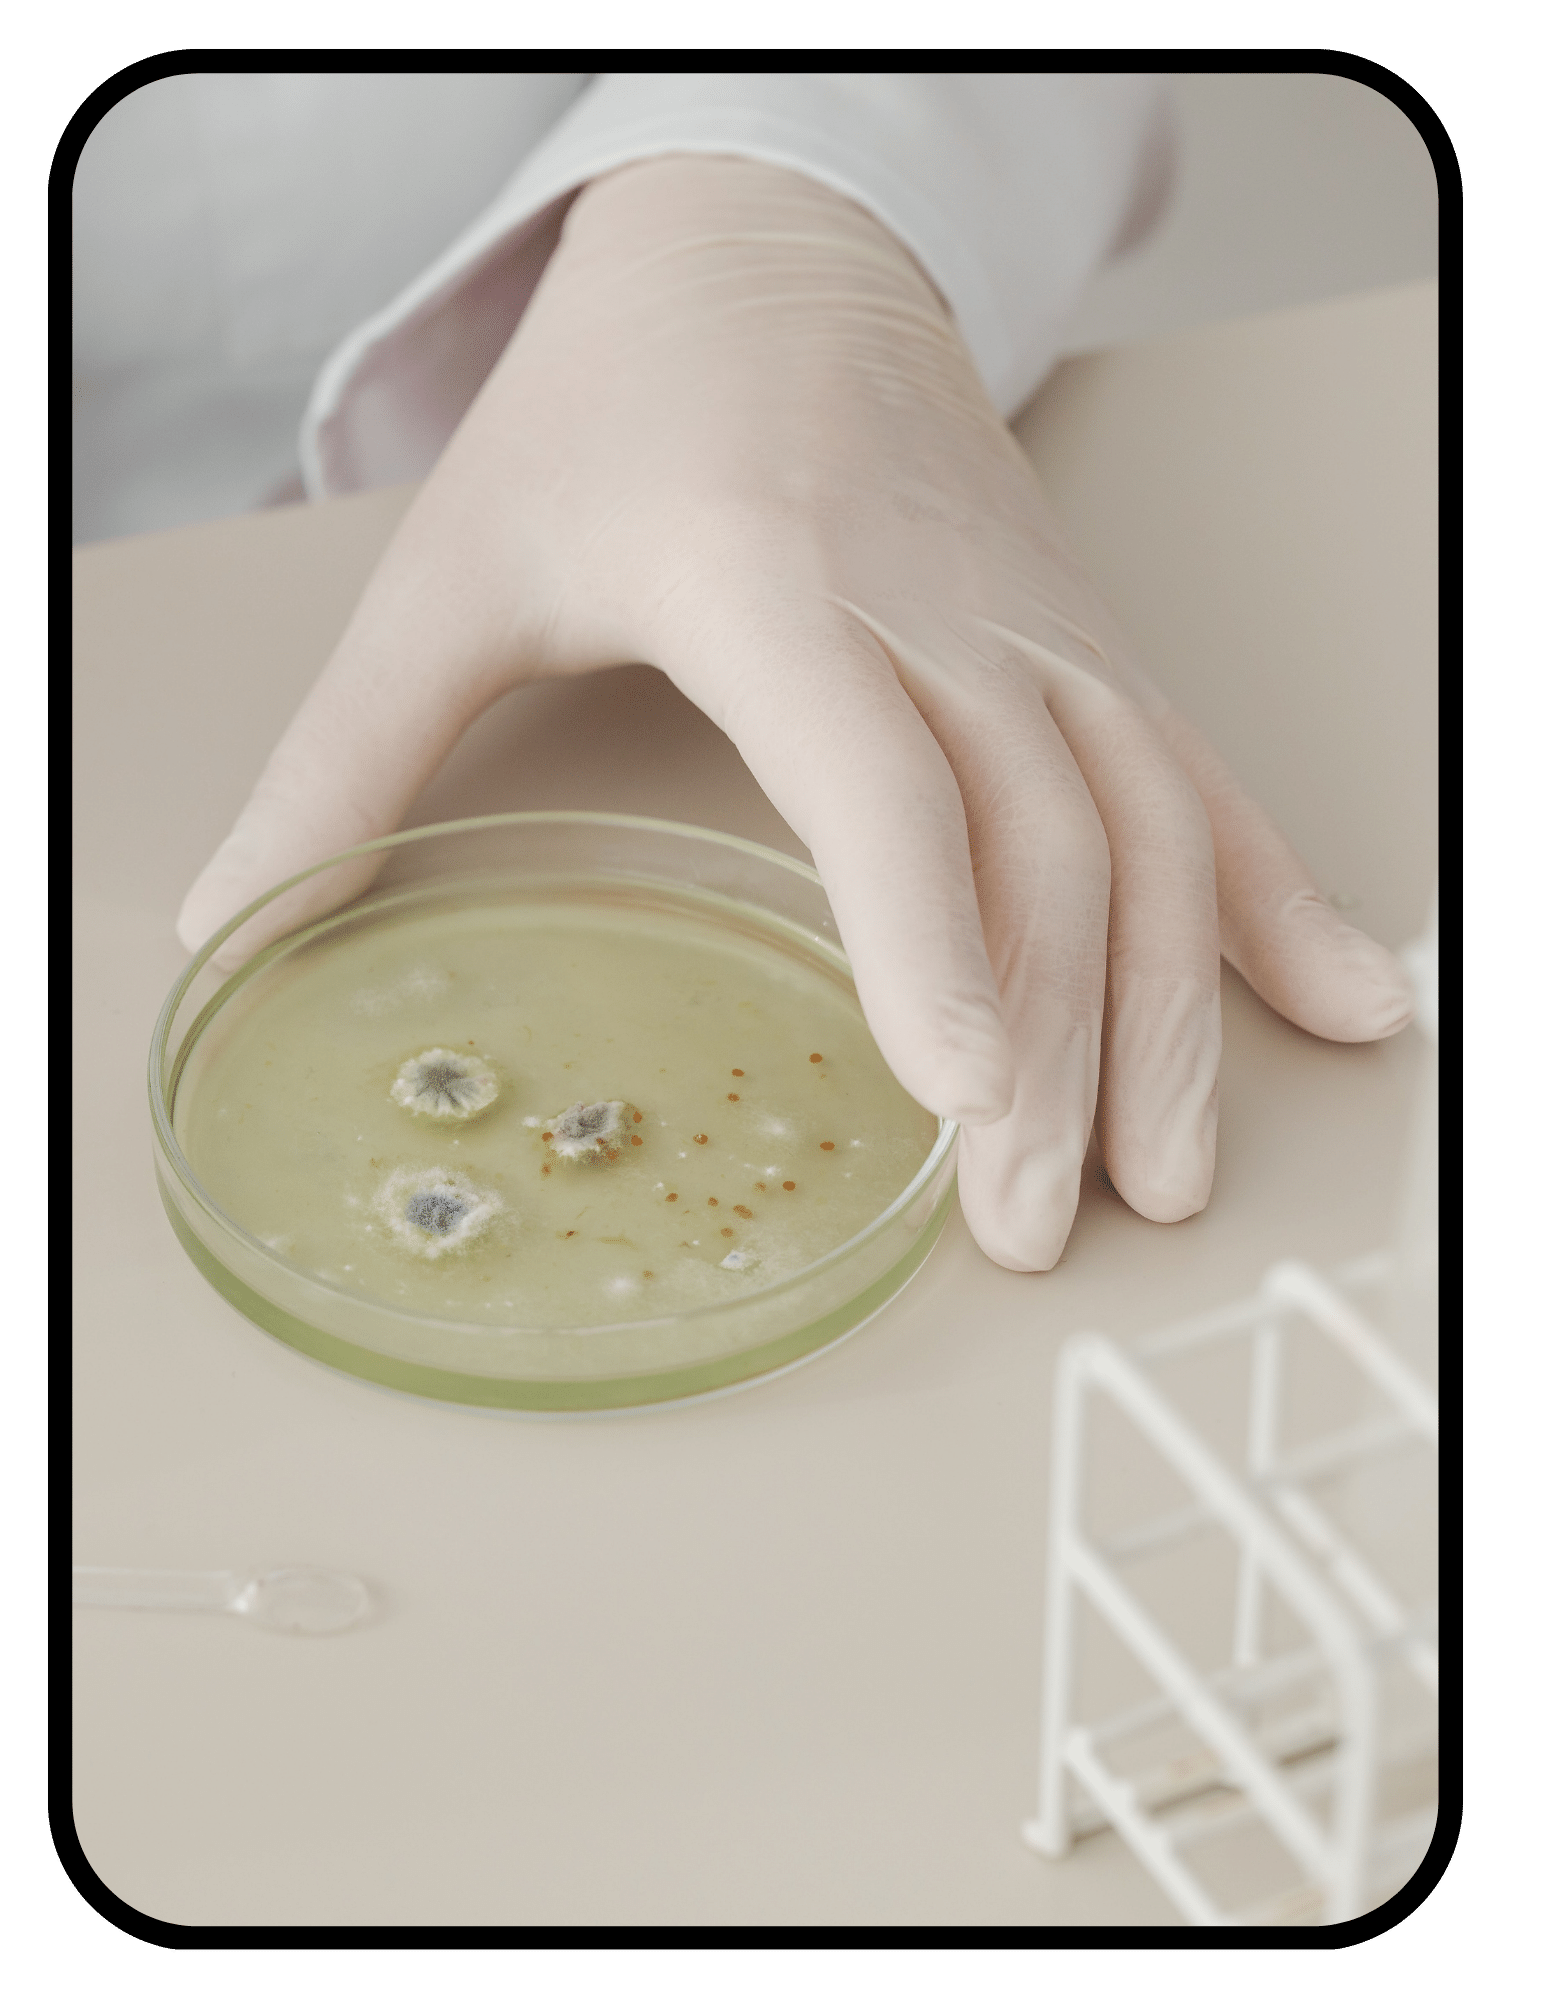

Learn ➜ Tools & References ➜ Home Testing
Home Testing

Dr. Meg Christensen is the founder of Interior Medicine, a physician-created resource on non-toxic home products and household exposures. Her layer-by-layer analysis of materials and products draws on her background in medicine, biochemistry, epidemiology, and clinical research.
Updated February 2026
Test kits for air, water, mold, and toxicants in your home, and a list of professionals who will do it for you when test kits aren’t accurate.
Mold Testing: ACAC Professionals Database
Mold test kits for home use are notoriously unreliable— because mold spores are everywhere in this world, including your home, these kits will always capture spores, often raising false alarm. While it can be a helpful starting point, and while some kits (like ERMI) are better than others, they still need to be interpreted in the context of water damage, requiring a professional inspection. But of course, not all mold pros are properly trained, and some have conflicts of interest because they’re also offering remediation. Enter ACAC. This is an amazing database of mold inspectors, remediators, and other professionals that are third party certified experts with extensive training. Search by zip code.
Material Testing: SimpleLab Test Kits
SimpleLab offers advanced at-home testing for an amazing number of toxicants, irritants, and allergens. You can test for PFAS in couch upholstery or other textiles, indoor allergens, heavy metals and microplastics in just about anything, and other tests for your home surfaces, indoor air, personal care products, outdoor soil, or tap water. SimpleLab owns MyTapScore, and so is also accredited, accurate, and reliable.
You can get a good picture of what’s in your tap water by checking your water quality through your city’s website or EWG's Tap Water Database. But, there are a few reasons you still may want to test your personal tap: if you have well water, aren’t sure about the state of your pipes and what they’re adding to the municipal water before it reaches your sink, are deciding between filtration systems, or want to understand if your water is contributing to any health issues. I recommend MyTapScore, because they only use acccredited labs, meaning the results are verified and accurate. They also win awards for customer service and ease of testing.
Indoor Air Quality Testing
I strongly recommend testing your indoor air quality. At a minimum, use a simple short term test kit for radon, which is the second leading cause of lung cancer in the US. Better yet, get a more complete picture of your indoor air, which is your greatest life exposure and can be surprisingly polluted— typically 5x worse than outdoor air. Here are the continuous indoor air quality monitors and radon detectors I recommend.
Learn ➜ Tools & References ➜ Home Testing